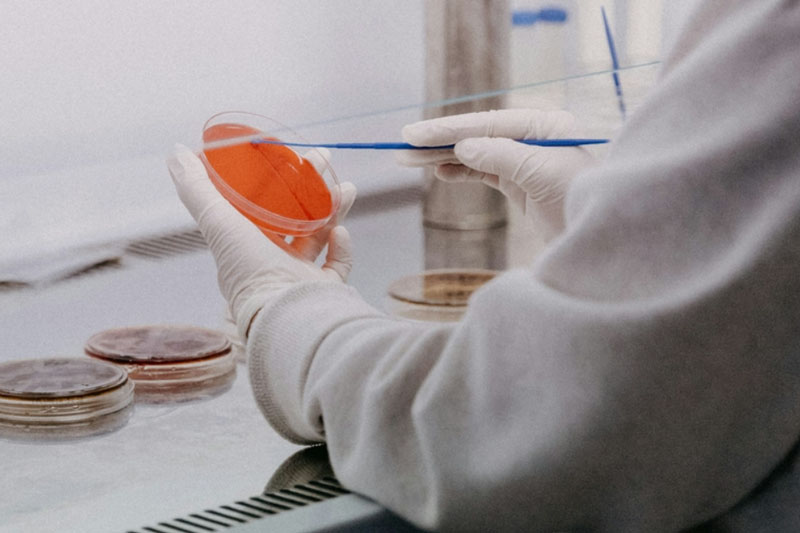
Прорыв в борьбе с ВИЧ: ученые нашли способ "рассекретить" вирус в клетках | Ученые из Мельбурна сделали ВИЧ видимым для лечения в лейкоцитах

Новости в мире
09 июня 2025 в 09:49
09 июня 2025
09 : 49
09 июня 2025 в 09:29
09 июня 2025
09 : 29
06 июня 2025 в 16:30
06 июня 2025
16 : 30
06 июня 2025 в 09:34
06 июня 2025
09 : 34
05 июня 2025 в 17:13
05 июня 2025
17 : 13
05 июня 2025 в 13:12
05 июня 2025
13 : 12
05 июня 2025 в 12:18
05 июня 2025
12 : 18
04 июня 2025 в 11:50
04 июня 2025
11 : 50
04 июня 2025 в 09:49
04 июня 2025
09 : 49
04 июня 2025 в 09:32
04 июня 2025
09 : 32
03 июня 2025 в 14:46
03 июня 2025
14 : 46
03 июня 2025 в 09:48
03 июня 2025
09 : 48
03 июня 2025 в 09:23
03 июня 2025
09 : 23
02 июня 2025 в 12:37
02 июня 2025
12 : 37
02 июня 2025 в 09:53
02 июня 2025
09 : 53
01 июня 2025 в 17:23
01 июня 2025
17 : 23
01 июня 2025 в 14:33
01 июня 2025
14 : 33
01 июня 2025 в 00:10
01 июня 2025
00 : 10
30 мая 2025 в 17:50
30 мая 2025
17 : 50